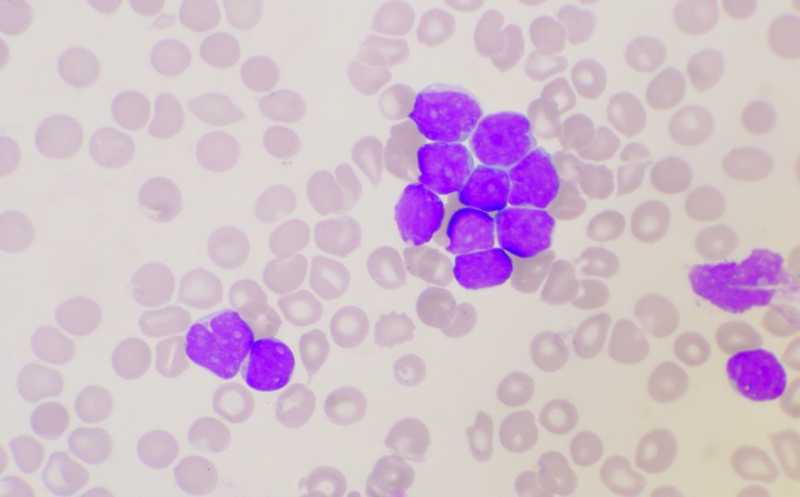

В редких случаях терапия CAR-T клетками может способствовать развитию T-клеточной лимфомы
Американские исследователи описали клинический случай пациента, страдавшего от неходжкинской B-клеточной лимфомы и получавшего коммерческую CAR-T терапию, у которого развилось вторичное злокачественное заболевание — T-клеточная лимфома. Клетки, давшие начало новообразованию, происходили от клона, который нес вариант гена JAK3 с неясной значимостью и присутствовал в крови пациента еще до инфузии CAR-T клеток. Однако воспаление, вызванное CAR-T терапией, могло спровоцировать его пролиферацию.
Авторы статьи, опубликованной в Nature Medicine, описали клинический случай пациента, который получил терапию коммерческим CAR T-препаратом, известным как аксикабтаген цилолеусел (Axi-cel, Yescarta, компания Gilead), и в течение трех месяцев после инфузии у него развилась T-клеточная лимфома.
В последние месяцы активно обсуждается безопасность CAR T-терапии. Управление по контролю продуктов и лекарств США (FDA) инициировало проверку шести одобренных CAR T-препаратов против рецепторов BCMA или CD19. В число последних входит и зарегистрированный в России препарат Кимрия (Kymriah, тисагенлеклеусел) компании Novartis, и Yescarta компании Gilead. У пациентов, получавших препараты этого класса, были обнаружены новообразования, включая CAR-положительную лимфому; некоторые из них умерли. Риски связывают с лентивирусными или ретровирусными векторами, которые применяют при модификации Т-лимфоцитов для доставки в них гена САR.
FDA подчеркивает, что преимущества CAR Т-клеточной терапии по-прежнему превышает возможные негативные последствия (подробнее на PCR.NEWS). Тем не менее в январе производители получили уведомления от FDA с требованием добавить в инструкцию к препаратам предупреждение о риске вторичного рака. По состоянию на 22 января FDA получило 25 сообщений о злокачественных новообразованиях Т-клеток после CAR T-терапии.
Некоторые предыдущие оценки показали, что на протяжении 5 лет после инфузии CAR T-клеток вторичные опухоли развиваются примерно у 15% пациентов (большинство случаев не связано с терапией). С другой стороны, масштабное исследование с участием 340 пациентов, получавших CAR T-клетки, на протяжении более 1000 пациенто-лет наблюдения выявило вторичное злокачественное новообразование только у 16 человек (3,6%), и при этом ни в одной из 11 доступных биопсий не было обнаружено трансгена.
CAR T-клетки используются уже десятилетия, и не показано прямой связи между их применением и злокачественной трансформацией, отмечают авторы новой статьи в Nature Medicine; CAR T-терапия лечит рак, а не вызывает его. Тем не менее даже единичные случаи вторичного рака, которые могут быть спровоцированы лечением, требуют пристального внимания. В 2018 году те же авторы описали случай молодого пациента с В-клеточным острым лимфобластным лейкозом (ОЛЛ), который получил CAR T-терапию против CD19. Через 9 месяцев произошел рецидив — развился CD19-отрицательный ОЛЛ, причем злокачественные клетки экспрессировали CAR. Ген CAR был случайно введен в одну лейкозную В-клетку во время производства CAR T-клеток, и рецептор CAR связывался с CD19, маскируя его от распознавания терапевтическими клетками. Таким образом, в ходе терапии возникла устойчивая линия злокачественных клеток.
Новая статья посвящена пациенту, у которого развилась T-клеточная лимфома в течение трех месяцев после инфузии препарата аксикабтаген цилолеусел (Axi-cel, Yescarta), также нацеленного на CD19. CAR-T клетки были получены с помощью ретровирусной трансдукции, а роль костимуляторного домена в CAR играл CD28.
Пациент, 64-летний мужчина, страдал от неклассифицируемой B-клеточной лимфомы со свойствами как диффузной B-клеточной лимфомы, так и классической ходжкинской лимфомы. После химиотерапии первой линии у пациента случился рецидив, ему была назначена терапия пембролизумабом, которую пришлось прервать после семи циклов из-за развития аутоиммунного колита. После этого пациент получил анти-CD19 CAR-T терапию. К 14-му дню, как и ожидалось, количество CAR-T-клеток стало снижаться. Через три месяца наблюдалось излечение от классической ходжкинской лимфомы, однако позитронно-эмиссионная томография (ПЭТ) показала новообразование в правой нижней области легкого. Гистологический анализ после операции позволил описать его как плоскоклеточную немелкоклеточную карциному. Кроме того, в трех периферических лимфоузлах у пациента проявилась T-клеточная лимфома. После удаления новообразования в легком пациент получил четыре цикла брентуксимаб ветодина. Однако через пять месяцев после операции немелкоклеточный рак легкого рецидивировал, и через 18 месяцев пациент скончался.
Авторы работы провели детальное гистологическое исследования лимфоузлов, пораженных T-клеточной лимфомой. Как показало окрашивание на CD19 и PAX5, B-клеток в них не было. T-клетки имели цитотоксический фенотип CD8+ и несли необычный вариант гена JAK3 с неясным значением. В клетках немелкоклеточного рака легкого была выявлена мутация TP53 p.Y205C 172 c.614A>G, которая не присутствовала в других злокачественных клетках пациента.
Дальнейший анализ показал, что злокачественные T-клетки не несут гена CAR и происходят не от CAR-T клеток, а от клона, который также имел необычный вариант JAK3 и присутствовал в крови пациента еще до инфузии. Однако CAR T-терапия и вызванное ею воспаление могли активировать деление клонов T-клеток, которые дали начало T-клеточной лимфоме.
Ученые подчеркивают, что в этой связи особую важность представляют клоны с вышеупомянутым вариантом JAK3. Возможно, дополнительным фактором риска трансформации T-клеток стал пожилой возраст пациента и предшествовавшая химиотерапия.
Чтобы оценить, насколько часто вторичные новообразования, включая T-клеточную лимфому, развиваются после CAR-T терапии, авторы проанализировали данные по 449 пациентам, получившим разные коммерческие CAR-T препараты с января 2018 года по ноябрь 2023 года в Пенсильванском университете. Вторичные новообразования были обнаружены у 16 пациентов (3,6%); частота, рассчитанная для медианного времени наблюдения (10,3 месяца) составила 1,8%. Однако прогнозируемая частота в течение 5 лет достигает 17% (а если исключить немеланомные раки кожи, то 9,5%). Наиболее распространенными были вторичные солидные опухоли (12 случаев, прогноз заболеваемости на 5 лет — 15,2%). Гематологические раки развились всего у 1,1%, и прогноз на 5 лет не превысил 2,3%.
Источник
Ghilardi, G., et al. T-cell Lymphoma and Secondary Primary Malignancy Risk After Commercial CAR T-cell Therapy. // Nature Medicine, 2024, DOI: 10.1038/s41591-024-02826-w


 Меню
Меню





 Все темы
Все темы




 0
0











